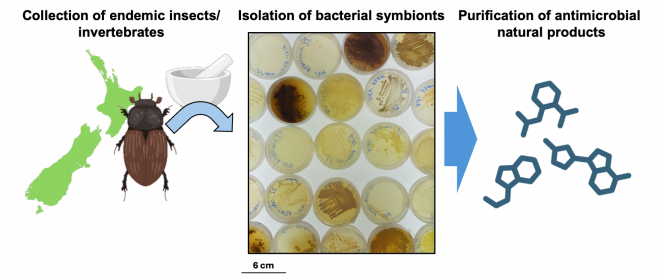

Drugs from the bugs within bugs: Harnessing the power of insect symbionts to combat antimicrobial resistance

As antimicrobial resistance becomes more prevalent, we desperately need new drugs to combat bacterial infections. Dr Rory Little from Te Herenga Waka— Victoria University of Wellington will explore the untapped potential of bacteria living on and in our native insects, to see if their chemical defences fit the bill
Published on 7 Whiringa-ā-rangi November 2024
Infectious bacteria are developing resistance to antimicrobial drugs at an alarming rate. Unless we can find a way to tackle resistance directly, we need to continue discovering and prescribing new drugs. Many of our most effective antibiotics are based on natural products that microbes produce to fend off competitors. Soil bacteria are particularly prolific producers of antimicrobials, but after decades of utilising this source, we have picked most of the low-hanging fruit. Are there other promising bacterial communities we could turn to for drug discovery?
Dr Little has been awarded a Marsden Fund Fast-Start grant to explore the untapped chemical potential of Aotearoa New Zealand’s insect symbionts, the bacteria that live on and inside our native insects. Some insect symbionts produce bioactive products that defend their hosts from infection, but this capability has not been explored in symbionts of our country’s own unique insect species. After receiving approval from mana whenua, Dr Little and his team will collect a diverse range of native insects and screen their bacterial partners for antimicrobial activity. They will then sequence the genomes of the bacteria with the greatest potential for producing bioactive compounds. Candidate antimicrobials will be isolated and characterised in more detail.
By discovering new antimicrobial agents with potency against resistant bacteria, this research could contribute to a solution to one of the world’s most pressing public health challenges. The identified bioactive compounds may lead to improved outcomes for patients in Aotearoa New Zealand and worldwide, ultimately saving lives. Furthermore, the genome information will provide a foundation for future studies on bioengineering novel synthetic drugs and characterising enzymes that can be used in chemical industries.
A summary of the workflow for this project. The central image shows agar plates with bacterial symbionts growing on them (image supplied)
